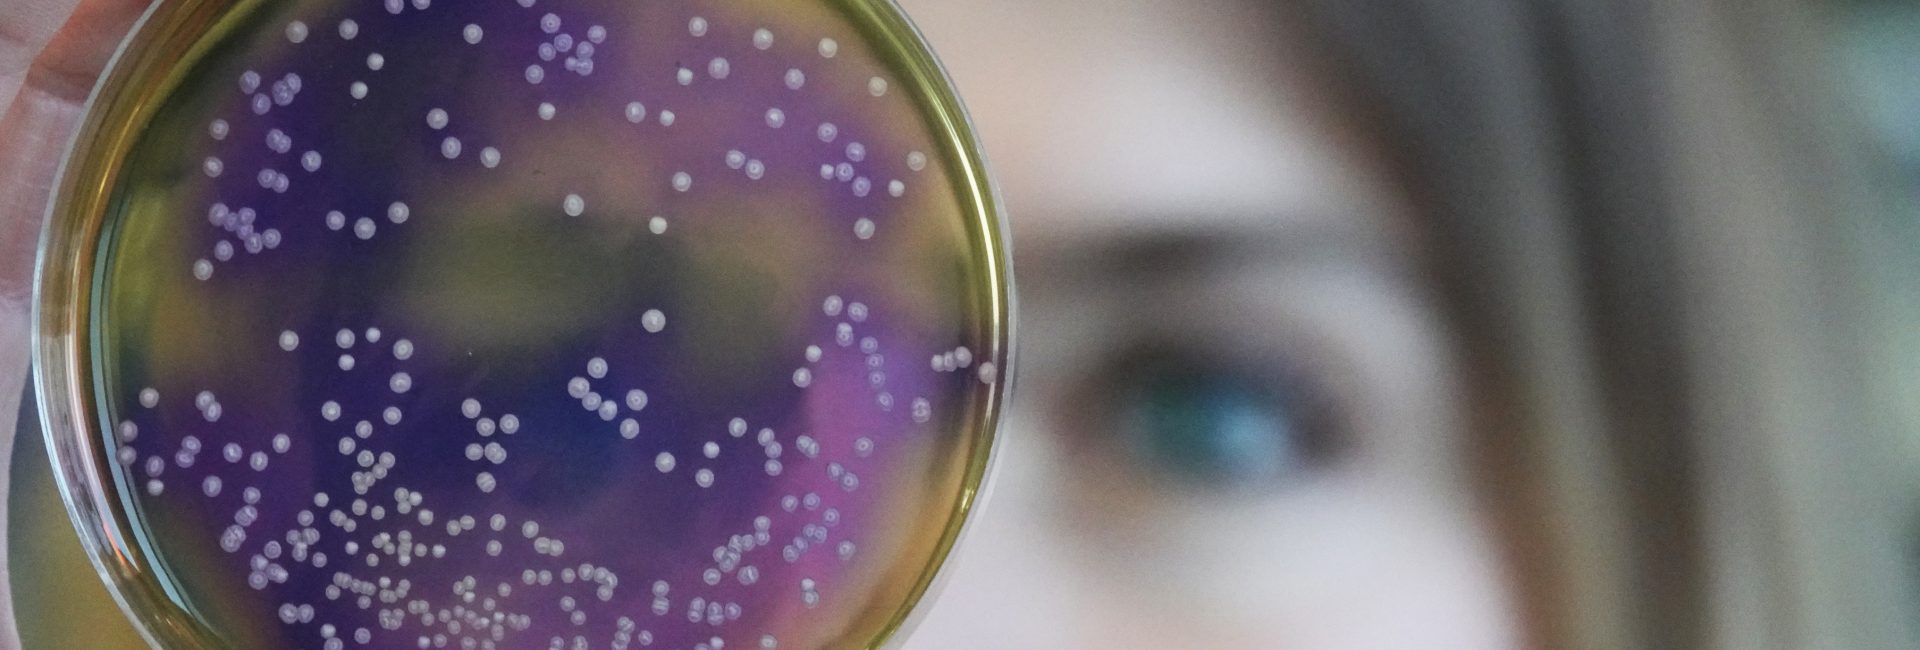

What was it like when oxygen killed almost all life on Earth?

- Although life appeared early on in Earth’s history, it wasn’t until around 2.7 billion years ago that the cyanobacteria, an early photosynthetic organism, began producing oxygen copiously.
- A waste product of photosynthesis, oxygen gradually began accumulating in the atmosphere over hundreds of millions of years, until all at once, it triggered “snowball Earth” conditions.
- For some 300 million years, Earth remained frozen, but the few living organisms that persisted continued to survive. When the ice melted, everything was different.
We commonly think of life on Earth as an unbroken chain of biological success, beginning shortly after our planet’s formation and continuing, unchallenged, for all the time since. Part of that story is true: it really was more than 4½ billion years ago that planet Earth formed, and it truly was just a few hundred million years later, at most, that life first arose on our world. Despite an enormous number of challenges that life has faced over all the time since — from resource scarcity to ice ages to asteroid strikes and a variety of mass extinction events — it has managed to persist without ever going extinct: not even once. Instead, life has thrived and evolved, enabling it to find a way to exist in practically every environmental niche that Earth possesses.
But one event came closer than any other to bringing an end to life on Earth: a catastrophe known as either the Great Oxidation Event or the Great Oxygenation Event. Oxygen, one of the hallmark characteristics of our living Earth, was a tremendous destructive force when it first arrived in any sort of meaningful abundance some ~2 billion years after Earth first took shape. The slow alteration of our atmosphere by the gradual addition of oxygen proved to be fatal to the most common types of organism that were present on Earth at the time. For several hundred million years, the Earth entered a horrific ice age which froze the entire surface: known today as a Snowball Earth scenario. This disaster almost ended life on Earth entirely. Here’s the story of our planet’s near-death, culminating in life’s ultimate survival story.

One of the earliest experiments high school students typically perform in a biology class is to observe and track the behavior of a small group of cells placed into a nutrient solution, with one classic example being the addition of yeast cells into a solution with molasses mixed into it. Observing the initial success — followed by the eventual failure — of the yeast colony holds many lessons for not just humanity, but for understanding the perils that organisms pose to themselves. At the start, the yeast organisms will initially become very successful, as
- food is abundant,
- there are no competitors for resources,
- and each individual cell can easily survive and reproduce.
If you count the living organisms inside as a function of time, you’ll observe that the number of active yeast cells will start growing exponentially, and the yeast population will explode.
But, in short order, all of that changes.
Yeast consume food through the chemically simple process of fermentation. The cells feed on sugar by converting it into alcohol, producing a few molecules of ATP (which can be used, metabolically, for energy), while also producing carbon dioxide as a waste product. Because the yeast live in an aqueous (i.e., water-based) environment, the addition of carbon dioxide to that liquid water results in the formation of carbonic acid. At some critical point, the environment itself becomes too acidic for the yeast cells to survive, and the population winds up crashing. If no external intervention is taken, the yeast colony will go extinct: poisoned by its own waste product.
This might be a simple biological scenario, but the lessons learned from it apply in a nearly universal fashion. In the presence of virtually no competitors or predators, and given practically unlimited resources, a living population of organisms will initially grow at an exponential rate. It will:
- consume the available resources,
- produce whatever metabolic products arise from its biological activity,
- will then reproduce in greater-than-replacement-level numbers,
- and subsequent generations will continue the cycle in an ever-increasing fashion.
With each subsequent generation of organisms, the levels of resource consumption rise, the metabolic products continue to increase in number and in concentration, and the total population of organisms continues to grow and grow. So long as resources are freely available and the environment remains non-toxic to the population of organisms present, this process will continue.
There’s always a limit, however, as there are always a finite number of resources in any given environment. At some point, the metabolic processes these organisms use to drive their life functions will produce a sufficient amount of “waste product” that builds to a critical level: eventually creating an environment that’s toxic to the population of the organism that produces it. If this sounds like what the yeast does to itself — or what modern humans are doing by deforesting the Earth and burning fossil fuels — you’ve put the pieces together correctly. Organisms, if left unchecked, always wind up poisoning their habitat with the waste products of their own success.

Human beings, and even yeast cells, unfortunately, are not the first organisms to encounter this very problem. In the very early stages of our Solar System, right here on planet Earth, a simple form of prokaryotic life arose: unicellular (single-celled) organisms. Although we don’t know the properties of the hypothesized protocells that theoretically gave rise to the first unicellular organisms, there is clear evidence of unicellular bacteria within the first billion years of Earth’s history, evidence of fossilized life dating back hundreds of millions of years earlier, and zircon crystals in ancient rocks that push the evidence for life back even earlier: to around 4 billion years ago.
One of the hallmarks of biological evolution, at least as we understand it, is that life will mutate, evolve, and diversify to fill every available ecological niche that’s plausible. From these earliest life forms, archaea arose, able to survive in the deep sea around hydrothermal vents. Plasmids, which carry genes responsible for novel abilities, arose as independent DNA molecules, unattached to the bacterial chromosome itself. Horizontal gene transfer and conjugation provided a way for genetic information to enter an organism’s genome, even without sexual reproduction. And at some point, hundreds of millions of years after the very first organisms arose, the first fully photosynthetic organisms came into existence.

By the time we fast-forward the clock to arrive at a mature Earth, some 3.4 billion years ago, the first evidence for photosynthesis occurring in living organisms starts to appear. There are a number of different pathways for photosynthesis to occur (and several types of chlorophyll molecule that enable the process on a molecular level), but all involve a very similar process. What happens is:
- incoming sunlight of a specific, particular wavelength,
- strikes a molecule (such as one of the chlorophylls) that is capable of absorbing it,
- which excites an electron in that molecule into a state high above the ground state,
- which will eventually de-excite,
- releasing energy in the process,
- and where that released energy can then be used in life processes.
Many organisms, such as green and purple sulfur and nonsulfur bacteria, make use of a variety of molecules to provide the electrons in their reactions, including hydrogen, sulfur, and numerous acids. But a class of organisms also evolved that use simple water as the electron donors for these reactions: the cyanobacteria, also known as blue-green algae. Unlike the other (generally, but not universally, thought to be earlier) organisms, cyanobacteria also produce molecular oxygen as a waste product. First arriving on Earth somewhere between 2.7 and 3.5 billion years ago, cyanobacteria became especially abundant approximately two billion years after Earth’s initial formation.

Cyanobacteria still survive today, and are extremely notable as the only photosynthetic prokaryotic organisms that produce oxygen. They seem to be more evolved (with longer, more complex genomes) than the other, non-oxygen producing photosynthetic prokaryotes, including all the other types of photosynthetic bacteria mentioned earlier. These blue-green algae organisms possess internal membranes (unlike the others), form microbial mats along the oceanic surface, and were very abundant on Earth no later than 2.5 billion years ago. Although stromatolite formation, thought to be ancient evidence for cyanobacteria, may date to a billion years prior, the evidence for the rise of cyanobacteria comes from a very different set of measurements.
The critical evidence? The contents of Earth’s ancient atmosphere, which is preserved in a variety of formats, such as ancient rocks and ice cores. The atmosphere, somewhere between 2.5 and 3.0 billion years ago, began to display evidence for having free oxygen present within it. Slowly but surely, the oxygen content began to build, and organisms with a seemingly unlimited resource — sunlight — began to undergo the same cycle that yeast cells and humans take:
- consuming resources,
- creating metabolic products,
- thriving and reproducing,
- and adding waste products to their environment.
Unfortunately, the waste product of oxygen, in this context, led to catastrophe. Oxygen, you see, is not just corrosive, an aid in combustion, and a chemical oxidizing agent; it’s also the cause of the greatest climate disaster in history: the Huronian Glaciation.

The way this climate disaster came about is instructive to anyone who wishes to avoid a similar disaster in the present. The cyanobacteria, experiencing the massive success of having an unlimited nutrient source wherever sunlight strikes the surface of the ocean, evolved into microbial mats in short order. Once they began producing oxygen, the early presence of that molecule systematically removed the early methane from Earth’s atmosphere, as oxygen reacts with methane to produce carbon dioxide and water. The loss of that early methane — a fabulously efficient heat-trapping molecule — greatly decreased the greenhouse effect from Earth’s early atmosphere: causing global temperatures to begin to drop.
At the same time, the oxygen produced by the cyanobacteria killed off most of the other, non-oxygen-using life forms, as oxygen, a corrosive agent, was toxic to them. The only reason that Earth was a temperate, liquid-water-covered planet at this time was because of that early greenhouse effect and the homeostasis of life during those times. The Sun’s energy output, like that of all stars, was much lower in the early stages of its life, and so the large abundance of atmospheric methane was the only thing keeping Earth warm enough to have liquid water on its surface. With the oxygen destroying that powerful greenhouse gas, the planet couldn’t retain its heat nearly as well. This spawned the greatest ice age in history, leading to Snowball Earth conditions that lasted for approximately 300 million years.

The geological evidence is overwhelming for incredibly cold conditions covering the entire planet at this time. Glacial deposits throughout northern North America (but also found as far away as Australia) display multiple sedimentary layers that show evidence for this frozen period persisting for long periods of time, spanning ages that correspond to being between 2.5 and 2.0 billion years ago. Evidence for past glaciation events, where glacial deposits must have been made even at then-tropical (i.e., equatorial) latitudes, has been very strong for more than half a century.
These Snowball Earth conditions aren’t just hazardous to life, but are a warning sign for all intelligent life to come, as the conditions that lead to a Snowball Earth are very easy to recreate. Once you cool the Earth and remove its heat-trapping atmospheric layers, further cooling appears to be a runaway process. If ice sheets advance far enough down below the polar regions, it increases the total reflectivity of the planet, which translates into less solar energy being absorbed by the Earth overall. The further cooling leads to the formation of even more ice, which can eventually cover the entire surface of the planet — continents and oceans both included — in a global layer of ice. That’s what a “Snowball Earth” set of conditions looks like.

As catastrophic as this was for most of the organisms that lived on planet Earth at that time, however, the chain of life didn’t come to an end at that moment. Despite the poisoning of their own environment, the cyanobacteria continued to thrive in at least some environments on Earth: perhaps where the ice was shallowest. Meanwhile, smaller populations of other organisms, facing tremendous selection pressures and a changing environment, evolved in different directions. Horizontal gene transfer led to more complex creatures, and those that accumulated large numbers of genes and novel abilities stood better chances of surviving, becoming more resilient to changes in their environment.
It was geology, however, and not biology, that eventually led to the end of these Snowball Earth conditions. Even as the planet remained frozen, plate tectonics continued, as continental drift, seafloor spreading, earthquakes, and volcanic eruptions all persisted. In particular, volcanoes continued to erupt beneath the ice, spewing those volcanic gases upward, where they would lead to cracks and fissures in the ice sheets. As volcanoes add copious amounts of carbon dioxide to the atmosphere, they began increasing the strength of the planet’s greenhouse effect once again, while the simultaneous production of ash began to decrease the reflectivity of Earth. Eventually, after approximately 300 million years, our planet finally broke out of this glaciation era.

Although it lasted for approximately 300 million years, the end of the Huronian Glaciation coincides with a remarkable development in the complexity of life: the first evidence for eukaryotic cells. The cells that now existed now boasted enclosed, separated organelles that could carry out life functions that were independent of the remainder of the organism. Eukaryotes, with well-defined specialized cellular machines within them, would later give rise to all the extant protists, plants, fungi, and animals that exist today. Although much remains to be learned about the evolutionary process during these Snowball Earth conditions, it’s arguable that human-like life would never have arisen if oxygen had never destroyed our methane-rich atmosphere and given life the opportunity to evolve in this spectacular, unique direction.
The period of time corresponding to 2.5 billion years ago in Earth’s natural history may yet represent the greatest mass extinction our planet has ever faced. Even at this primitive stage, however, life remained ubiquitous and resilient, with the destruction of the pre-existing dominant species enabling other, new organisms to evolve and rise to prominence, filling those now-vacant ecological niches. The Great Oxygenation Event was a transformative occurrence in Earth’s history, and may have paved the way for complex and differentiated life on our world. Without it, life may never have achieved the diversity it now boasts today, and the tree of life may not have been capable of giving rise to intelligent, advanced organisms like us.